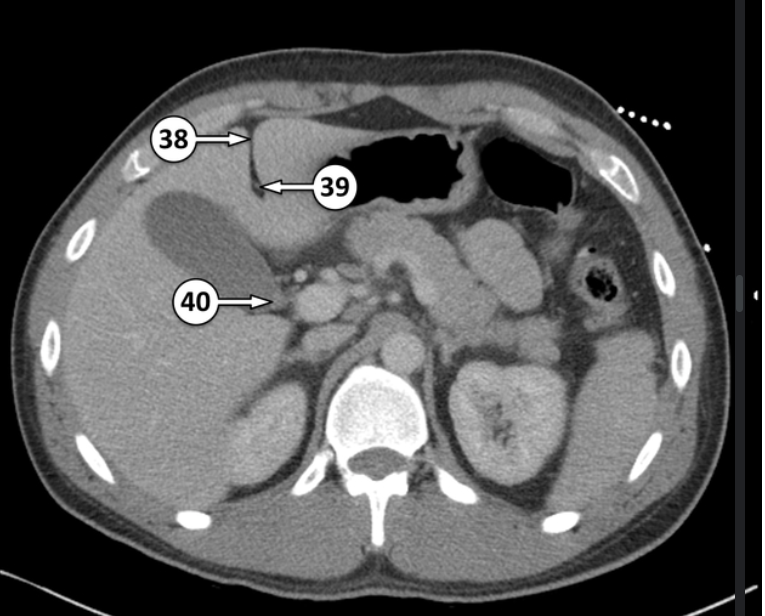
<p>What is 38 and 40?</p>

HMI202 - Imaging test?
1/51
Earn XP
Description and Tags
chat i might be cooked
Name | Mastery | Learn | Test | Matching | Spaced | Call with Kai |
|---|
No analytics yet
Send a link to your students to track their progress
52 Terms

This is a double contrast examination. What is it showing?
A peptic ulcer that is on the posterior wall of the antrum









What does this image show?
Giant gastric ulcer that is located more proximally in the stomach

Please label




Please label


Please label


What gland is this?


What arteries are these?


Please label the following arteries


What is this artery and vein?


Label the CT abdomen
right hemidiaphragm
segment VIII of the liver
inferior vena cava

Please label 5 and 6
left hepatic vein
right hepatic vein

Please label 9
Gatstric fundus

10 and 11 are segments of the liver. Label which segments they are
segment II of the liver
segment IV of the liver

Please label 18 and 19
Segment III of the liver
Left Hepatic artery

20 and 21 are both blood vessels. Label which blood vessels they are
right portal vein
right splenic artery

Label 23 and 24
Segment V of the liver
Splenic vein

Label 25 and 26
Common hepatic duct
Segment VI of the liver

What is 27 and 28?
Splenic flexure
Left gastric artery
What is 38 and 40?
Falciform ligament
neck of the gallbladder

Label 41 and 42
main pancreatic duct
body of gallbladder

Please label parts of the gallbladder


Label


Label


Please label the internal carotid artery (ICA)


Label the circle of willis


Please label the circle of willis


Please label

The fundus of the gallbladder is connected to which part of the liver?
Right liver lobe between segments IV and V

Label the arteries in the small intestine


Label the arteries


Label the coronary angiogram


Label


Please label the reconstructed MR angiogram


Please label this coronal CT scan


Please label the aneurism in the aortic arch


Please label the lateral view of the heart


Please label the anterior view of the stomach


Please label






Please label what 8 and 9 is, and what type of epithelium they are
Body of stomach, simple columnar with parietal and chief cells
Transverse colon, simple columnar

Please label 14 and what is it’s function
Falciform ligament, and it’s separates the liver into it’s anatomical left and right lobes on the anterior view

No. 16 is ileum of the small intestine. Please label the epithelium type and it’s function
Simple columnar + peyer’s patches
absorbs remaining nutrients

24 is a part of the pancreas. Please label the specific part and the epithelium associated
Neck of pancreas + simple columnar epithelium

What artery is number 47?
Right hepatic artery

48 and 49 are flexures. Please label the different flexures
Splenic flexure
Duodenojejunal flexure

Please label 55 - 58
right portal vein
left portal vein
common bile duct
uncinate process of the pancreas